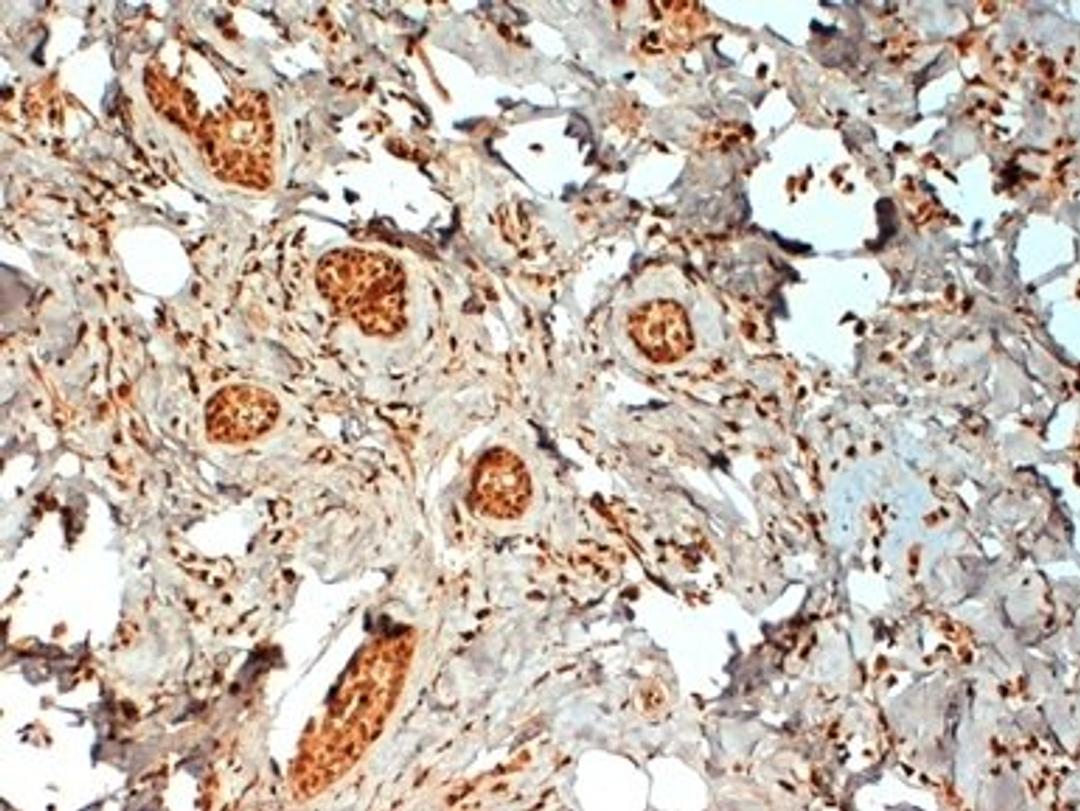
FFPE human breast cancer biopsy stained with Mouse anti Human estrogen receptor beta 2 antibody

MOUSE ANTI HUMAN ESTROGEN RECEPTOR BETA 2
Product Details
- Cat. No.
- MCA2279GT
- Type
- Primary Antibody
- Clonality
- Monoclonal
- Host
- Mouse

The supplier does not provide quotations for this antibody through SelectScience. You can search for similar antibodies in our Antibody Directory.
Description
Mouse anti Human Estrogen Receptor beta 2 antibody, clone 57/3 recognizes the estrogen receptor beta 2 isoform, expressed in cell nuclei of a range of human tissues including the ovary, placenta, testis and vas deferens. No cross-reactivity is seen with estrogen receptor beta 1 isoform. The detection of estrogen (ER) and progesterone (PR) receptors using immunohistochemical staining of formal fixed paraffin embedded (FFPE) tissue, has gradually replaced ligand binding assays (LBA), to become the most common method for the determination of the ER/PR status of breast tumors. Approximately 75% to 80% of breast tumors have estrogen and/or progesterone receptors, and the presence of these receptors helps determine both the patient’s prognosis and the effectiveness of hormonal therapy
Biological Information
- Clonality: Monoclonal
- Host: Mouse
- Reactivity: Human
- Isotype: IgG1
Handling
- Quantity: 50 µg
- Storage: +4ºC, -20ºC if preferred
- Buffer: Phosphate buffered saline, 0.09% Sodium Azide
Applications
- Immunohistochemistry (Paraffin-Embedded Sections) (IHC (P))